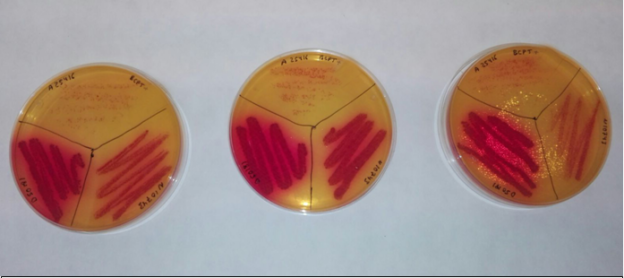
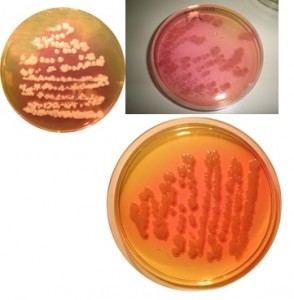
bcpt
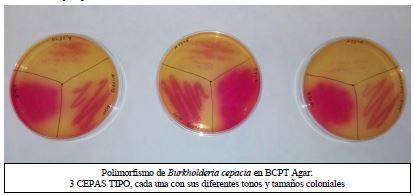
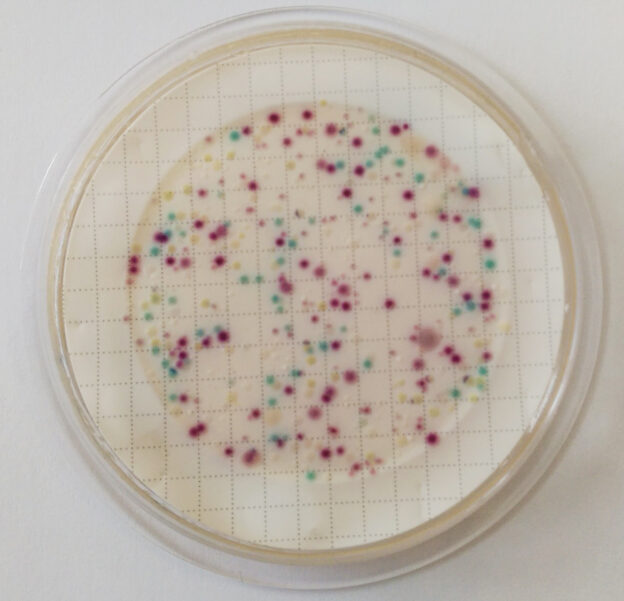
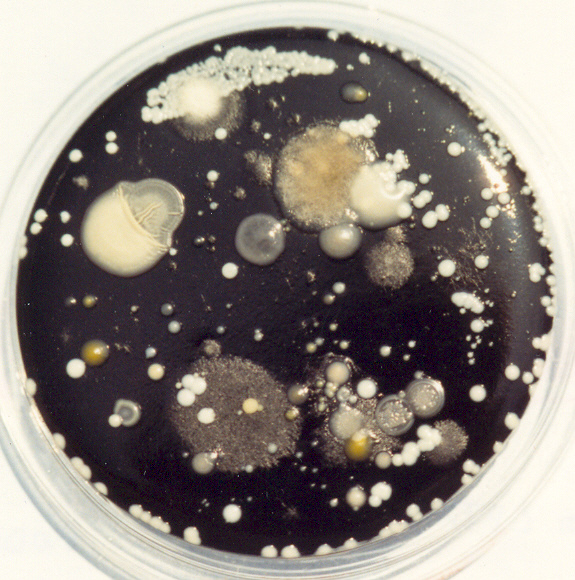
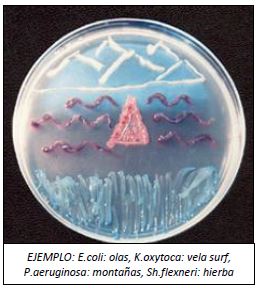

ANAEROTECA (KPX004)
Algunas cepas de microorganismos se resisten a mantenerse en los sistemas de congelación clásicos y comerciales de las tres marcas mundiales (En España, C RIOTECA® de MICROKIT); no es un problema del producto sino de la cepa. MICROKIT diseñó hace ya tiempo una CRIOTECA® especial para hongos como las levaduras (CRIOTECA®-YM), otra para halófilos como Vibrio (CRIOTECA®-MAR) y otra para microorganismos de crecimiento difícil como las micobacterias (CRIOTECA®-SKIM MILK). Sin embargo, seguía existiendo un grupo problemático: Los anaerobios.
RIOTECA® de MICROKIT); no es un problema del producto sino de la cepa. MICROKIT diseñó hace ya tiempo una CRIOTECA® especial para hongos como las levaduras (CRIOTECA®-YM), otra para halófilos como Vibrio (CRIOTECA®-MAR) y otra para microorganismos de crecimiento difícil como las micobacterias (CRIOTECA®-SKIM MILK). Sin embargo, seguía existiendo un grupo problemático: Los anaerobios.
Tras un año de intensos estudios presentamos la solución: ANAEROTECA, basada en el mantenimiento durante meses SIN CONGELACION, que era precisamente la que impedía su viabilidad en los sistemas criogénicos.
Los anaerobios se mantienen muy mal en medios normales refrigerados o congelados. Presentamos los tubos de ANAEROTECA, rellenos con 18 ml (máxima profundidad) de un medio especialmente diseñado por MICROKIT para la conservación de la mayoría de anaerobios (sobre todo Clostridios) y que ha resultado el mejor en un estudio interno entre 8 variantes.
El medio contiene agentes reductores para que la penetración del oxígeno del aire sea mínima.
Además, la resazurina avisa de cuándo la oxidación del medio alcanza niveles peligrosos para la viabilidad de los microorganismos almacenados: Si más de la tercera parte del tubo está de color rosa, se debe regenerar hirviéndolo 10 minutos. En el caso de que la cepa esté ya inoculada, hervir otro tubo vacío e inocularlo con una gota del fondo del tubo inoculado que se ha oxidado, no agitado.
Las partículas sólidas de Cooked Meat Granules resultan un hábitat ideal para el mantenimiento de la mayor parte de los anaerobios más usuales en microbiología de alimentos y de aguas.
La infusión de cerebro y corazón permite el mantenimiento de la mayor parte de anaerobios patógenos humanos.
MODO DE EMPLEO
- Inocular la cepa pura (colonia, suspensión espesa o liófilo frescos) en el fondo. Si se trata de esporulados (Clostridium) realizar un duplicado sometido a un shock térmico adecuado (10 minutos a 75 ºC…) para permitir la germinación.
- Cerrar y no agitar ni voltear, para mezclar, evitando la agitación brusca que oxigenaría el medio. Registrar los datos.
- Mantener a temperatura ambiente (ideal 21-25 ºC).¡NO CONGELAR! ¡Ni siquiera refrigerar! El frío permitiría la rápida oxigenación del medio, comprometiendo la viabilidad de los anaerobios.¡NO AGITAR!.
Cuando necesite cepa pura, tome con una pipeta Pasteur una gota del fondo (mejor si lleva trozos particulados) e inocúlela en el medio adecuado. Incube de la forma más adecuada para la cepa en cuestión.
Algunas cepas pueden mantenerse en ANAEROTECA durante años, otras sólo algunos meses: Resiembre duplicados en ANAEROTECA hasta conocer el tiempo límite normal de viabilidad de sus cepas.
CRIOTECA®-MIX-ENANA-50 es una referencia que incluye 10 Crioviales clásicos (para todo), 10 Skim Milk (para todo y micobacterias), 10 YM (para hongos y levaduras), 10 Aquática (mejor para Legionella, Pseudomonas, Staphylococcus, E.coli…), 5 Halófilos (Vibrio parahaemolyticus…) y 5 Campy, Ref.: KPX200. Palillos estériles para tomar mejor las bolitas: VDP099.
CAJA VACIA CRIOBOX PARA 100 CRIOVIALES, y para poder tener una parte de la CRIOTECA® congelada y los viales no inoculados, sin congelar. Ref.: VPX453. Idem porexpán , Ref.VPX500.
El usuario es el único responsable de la eliminación de los microorganismos según la legislación medioambiental vigente. Autoclavar antes de desechar a la basura.
Diseñado y fabricado por MICROKIT desde1995. CRIOTECA® es marca registrada de MICROKIT.
Revisado en Diciembre de 2019.